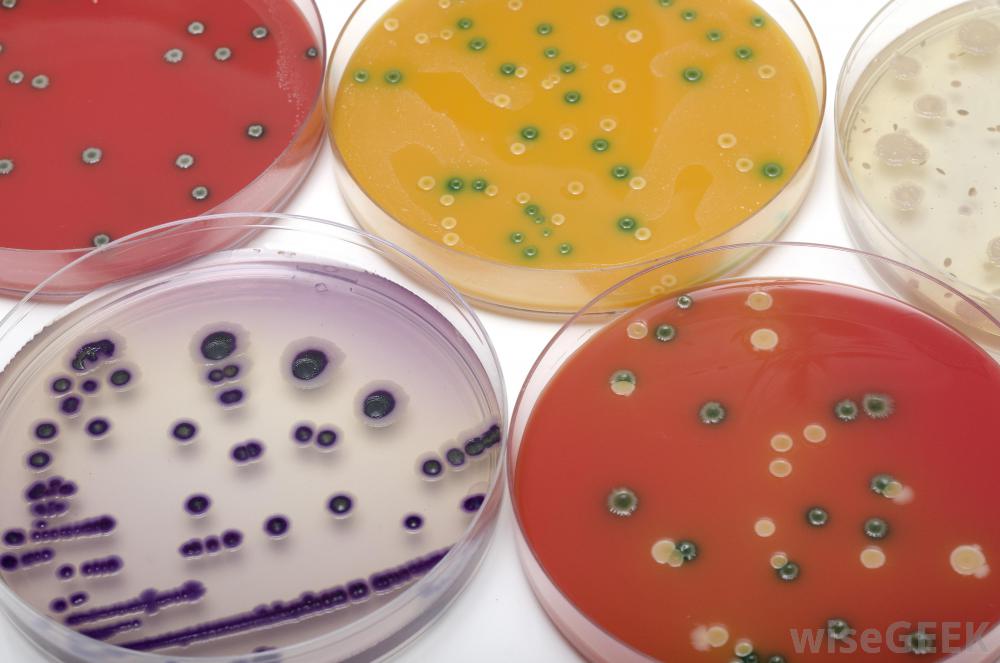

需氧菌是微小的單細胞生物,是細菌的一種。由于這些細菌需要氧氣才能生存和生長,這是這些微生物的決定性因素。相比之下,不需要氧氣,甚至受到氧氣傷害的細菌,被稱為厭氧菌。 結核病通常影響肺部并引起盜汗和發燒。 好氧細菌...
需氧菌是微小的單細胞生物,是細菌的一種。由于這些細菌需要氧氣才能生存和生長,這是這些微生物的決定性因素。相比之下,不需要氧氣,甚至受到氧氣傷害的細菌,被稱為厭氧菌。

結核病通常影響肺部并引起盜汗和發燒。
好氧細菌與環境進行氣體交換。這種氧氣的攝入對消化和細菌內部發生的其他能量消耗過程至關重要。所有動物,包括人類,也需要氧氣的持續存在,因此,人類和這些細菌有著相同的棲息地。需氧菌非常豐富,它們實際上是地球上數量最多、分布最廣的有機體。在有足夠氧氣和某種形式的物質作為食物來源的地方,需氧菌很可能就存在。

許多種類的需氧菌和厭氧菌都能促進健康和預防疾病。
一種臭名昭著的需氧菌是結核分枝桿菌,肺結核引起肺結核的有機體。肺結核是一種或多種結核分枝桿菌被吸入并在宿主體內成功繁殖,特別是在肺部。由于結核桿菌是有氧的,嗜氧的,免疫系統有限的個體的肺是一個好客的棲息地,大多數健康人都有免疫系統,可以防止這些需氧菌在體內停留并引起感染

肺結核是一種需氧菌,往往在肺部富氧的環境中茁壯成長。
,許多種類的細菌,包括需氧菌和厭氧菌,實際上可以促進健康和預防疾病。這些有益的細菌可以被認為是一支保護宿主免受更多致病微生物侵害的個人軍隊。細菌還負責不斷分解廢物,使養分返回土壤,使食物完整鏈。在這種作用下,細菌被歸類為分解者,它們在土壤中的存在對生態系統的健康至關重要。

肺結核的癥狀可能包括疲勞和咳嗽。
需氧菌繁殖通過一種叫做二元裂變的過程,也就是說,一個人可以復制自己并分裂成兩個完全相同的個體。正是這種不需要尋找合適的配偶就可以快速繁殖的能力,使細菌能夠導致許多可怕的感染。一個微小的細菌可以進入傷口或被吸入,如果條件合適,在數小時內就可以達到數百萬。實際上,是細菌產生的廢物起到了毒藥的作用,破壞了受感染者或動物的組織,而不是細菌本身。

呼吸痛可能是肺結核的癥狀。
有氧細菌是地球上分布最廣的生物。

需氧細菌需要氧氣才能生存和生長。